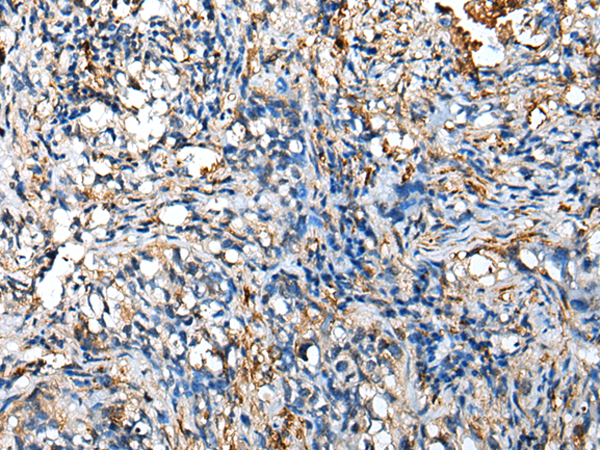
一抗

中文名稱: 兔抗NUDT4多克隆抗體
英文名稱: Anti-NUDT4 rabbit polyclonal antibody
別 名: DIPP2; HDCMB47P; DIPP2beta; DIPP2alpha
相關類別: 一抗
抗 原: NUDT4
儲 存: 冷凍(-20℃)
宿 主: Rabbit
反應種屬: Human, Mouse, Rat
標 記 物: Unconjugate
克隆類型: rabbit polyclonal
技術規(guī)格
|
Background: |
The protein encoded by this gene regulates the turnover of diphosphoinositol polyphosphates. The turnover of these high-energy diphosphoinositol polyphosphates represents a molecular switching activity with important regulatory consequences. Molecular switching by diphosphoinositol polyphosphates may contribute to regulating intracellular trafficking. Several alternatively spliced transcript variants have been described, but the full-length nature of some variants has not been determined. Isoforms DIPP2alpha and DIPP2beta are distinguishable from each other solely by DIPP2beta possessing one additional amino acid due to intron boundary skidding in alternate splicing. |
|
Applications: |
ELISA, IHC |
|
Name of antibody: |
NUDT4 |
|
Immunogen: |
Full length fusion protein |
|
Full name: |
nudix (nucleoside diphosphate linked moiety X)-type motif 4 |
|
Synonyms: |
DIPP2; HDCMB47P; DIPP2beta; DIPP2alpha |
|
SwissProt: |
Q9NZJ9 |
|
ELISA Recommended dilution: |
5000-10000 |
|
IHC positive control: |
Human lung cancer |
|
IHC Recommend dilution: |
25-100 |

 購物車
購物車 幫助
幫助
 021-54845833/15800441009
021-54845833/15800441009